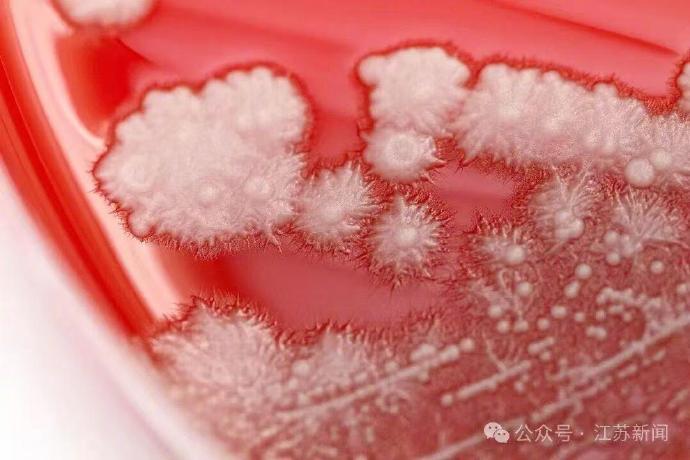

宁波36岁张先生喉咙痛,自行吃了点抗生素药物“消消炎”,谁知一个月过去,病不但没好,反而“雪上加霜”。 喉镜检查发现,张先生的整个咽后壁有一层白茫茫的“雪花”,最终他被确诊为真菌性咽喉炎,罪魁祸首不是细菌,而是白色念珠菌。 原来,从事销售工作的张先生每天都很忙,熬夜、出差都是常态,但凡遇上头疼脑热,他就到药店买点头孢或阿奇霉素吃。 “抗生素虽然能杀灭致病菌,但是它会不分青红皂白地把口腔里的‘好菌’和‘坏菌’一起杀光,白色念珠菌便会趁机疯长。”医生解释,而长时间的高压节奏也会导致身体免疫力下降,在多重因素影响下,最终引发了真菌性咽喉炎。医生提醒:抗生素不是万能药,若出现咽痛、发热等情况请及时就诊。